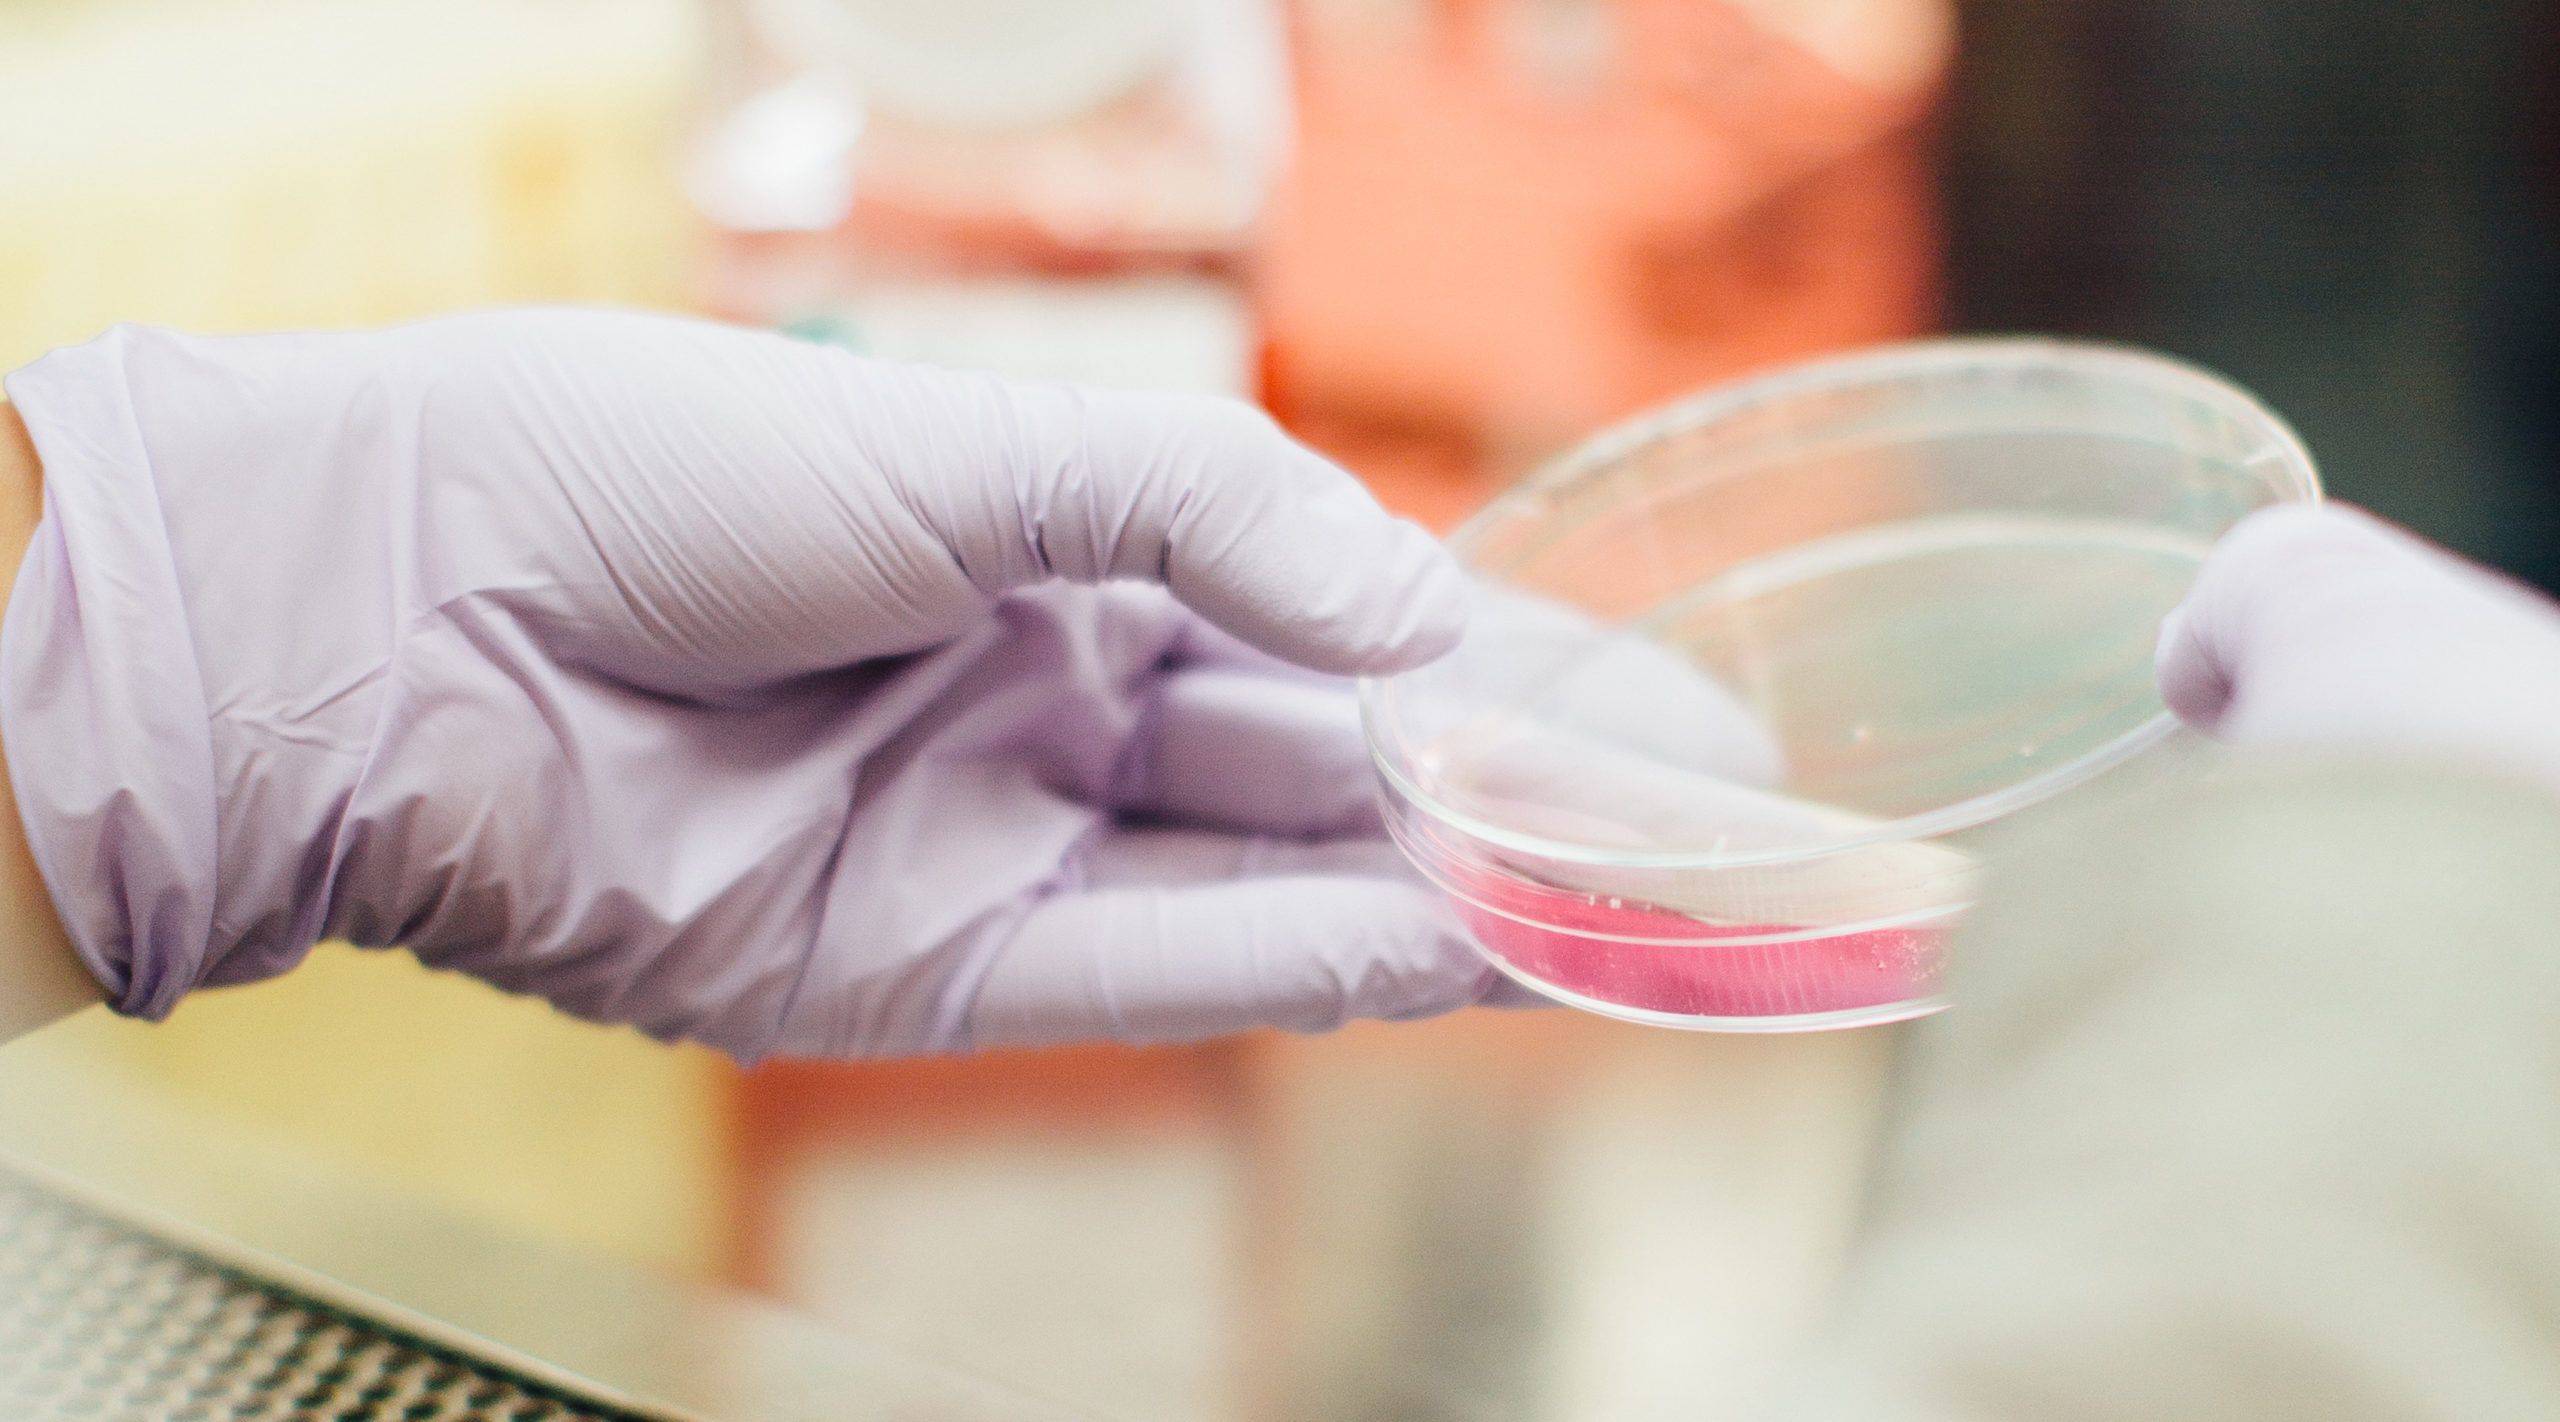
How do you create a diabetes management kit that fits modern lifestyles?

Results
Designed for people.Built for scale.Proven in practice.














ORGANIZATIONAL TRANSFORMATION
How do you create loyalty through elevated experience?

HEALTHCARE CUSTOMER EXPERIENCE
How can digital therapies improve health outcomes?

GROWTH STRATEGY
How do you combine design and business strategy to create new growth?

DESIGN STRATEGY
How do you capitalize on new market opportunities

DIGITAL EXPERIENCE INNOVATION
How do you take one of the world's largest e-commerce platforms to new heights?

DIGITAL HEALTHCARE EXPERIENCE
How do you launch a new service to empower chronic disease patients

MEDICAL PRODUCT EXPERIENCE
How do you reinvent the OR surgical team experience?

BUILDING MEDTECH BUSINESSES
What does the future of medical education look like?
HEALTHCARE CUSTOMER EXPERIENCE
How do you create a diabetes management kit that fits modern lifestyles

EDUCATIONAL EXPERIENCE
How do you support returning mothers in the workplace
Hey there, how's it going ?
Welcome to IA Collaborative. I can help shape a tailored path from strategy to shipped outcomes - What challenge are you trying to solve right now ?
Want to create the future of human experience?
Let's talk.

REDEFINING FINANCIAL SERVICES
Transforming a credit card network into a fintech innovator

DESIGN STRATEGY
Creating a framework for AI to do good

PANDEMIC RELIEF INNOVATION
Stopping the spread of deadly diseases through innovation

REDEFINING A PORTFOLIO
Differentiating a complex brand portfolio

BUSINESS STRATEGY
Building a designed conglomerate

LAUNCHING A NEW BUSINESS
Creating a visitor experience that's truly unique

DIFFERENTIATION THROUGH DIGITAL
Repositioning a brand through a better online experience

REIMAGINING USER EXPERIENCE
Designing services that make end-of-life planning easier

PRODUCT INNOVATION
Learning from athletes about new product strategy

UNIQUE DIGITAL EXPERIENCES
Using new digital experiences to drive ticket sales

CREATING A NEW BUSINESS
Launching a startup within a global CPG company

BUSINESS MODEL DESIGN
Evolving business clubs to become more relevant

BRAND STRATEGY
Brand identity as a force for growth

NEW PRODUCT OPPORTUNITIES
Redesigning a no-nonsense website for a professional audience

RETAIL EXPERIENCE DESIGN
Making tomorrow's smart home tangible today

NEW PRODUCT OPPORTUNITIES
Redefining the experience of music at home

PLATFORM DESIGN
Helping consumers track their everyday energy usage

BUSINESS STRATEGY
A new pet care offering that's in line with modern lifestyles

EMPLOYEE EXPERIENCE INNOVATION
Designing for the future of work

NEW PRODUCT OPPORTUNITIES
Universal design for product innovation

ELEVATING DESIGN AS STRATEGY
Launching a new category leader in less than 100 days

LAUNCHING A NEW BUSINESS
Redesigning an experience to attract a new audience

ELEVATING DESIGN AS STRATEGY
Scaling a beloved brand for future generations

CULTURAL EXPERIENCE DESIGN
Connecting an existing town with its future residents

DESIGN FOR NUTRITION
Helping people make better food choices

BRAND STRATEGY
Retooling a classic American brand for market dominance

INNOVATION CULTURE DESIGN
Translating internal innovation into external brand touchpoints

LIFESTYLE BRAND INNOVATION
Modernizing and expanding a classic lifestyle brand

UNCOVERING UNTAPPED OPPORTUNITY
Designing power tools that make a surgeon's job easier

CREATING AN ICONIC BRAND
Turning a housewares brand into a true icon

YOUTH CONSUMER STRATEGY
Portrait of a Young Athlete: Informing Global Brand Experience Strategy
Global Navigation
# IA Collaborative
> Navigation Map

